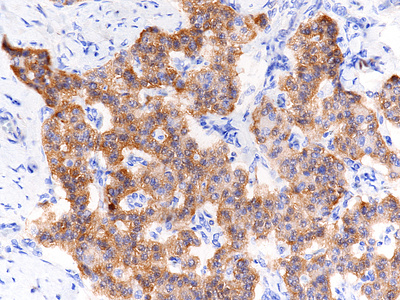

-
Die Universität
- Herzlich willkommen
- Das sind wir
- Medien & PR
-
Studium
- Allgemein
- Studienangebot
- Campusleben
-
Forschung
- Profil
- Infrastruktur
- Kooperationen
- Services
-
Karriere
- Arbeitgeberin Med Uni Graz
- Potenziale
- Arbeitsumfeld
- Offene Stellen
-
Diagnostik
- Patient*innen
- Zuweiser*innen
- Gesundheitsthemen
- Gesundheitsinfrastruktur
Case of the Month
June 2022
Pancreas resection in a 73-year-old male.
Diagnosis
Intraductal papillary mucinous neoplasm associated with a neuroendocrine tumour with expression of glucagon (IPMN-NET).
Comment
Upon magnetic resonance imaging (MRI) the pancreas contains several cystic lesions plus one partly solid, partly cystic lesion with a maximum diameter of 15 mm within the body. This lesion shows a biphasic pattern (Panel A). There are cysts lined by mucin-producing columnar cells with low grade dysplasia, consistent with a diagnosis of intraductal papillary mucinous neoplasm (IPMN). Other parts show a mainly solid, but also pseudoglandular growth of cuboidal cells with eosinophilic granular cytoplasm and centrally placed nuclei with “salt and pepper” chromatin and small nucleoli (Panels B-C). Mitoses are not detected. The two components merge with each other (Panel D), and in some foci the eosinophil granular cells underline the columnar cells (Panel E). The solid tumour component is strongly positive for synaptophysin (Panel F) and chromogranin A (Panel G), as are the underlining cells within the cystic component (Panel H). The Ki67 proliferation rate is low in the columnar epithelium (Panel I) and even lower (4%) in the solid component (Panel J). It is of note that the cells within the solid component express glucagon, while the cyst-lining mucus-producing cells are negative (Panels K-L).
A final diagnosis of intraductal papillary mucinous neoplasm associated with a well differentiated neuroendocrine neoplasm, that is, a neuroendocrine tumour (NET) grade 2, was made (IPMN-NET).
The occurrence of two distinct tumour types within the pancreas has only rarely been described in the literature. Our case is only the fourth case of a true mixed tumour with IPMN and NET components. Two previous cases have additionally been investigated by molecular pathology (Chen et al. Diagn Pathol 2021; Shiavo Lena et al. Virchows Arch 2021). The authors noted identical genetic signatures in both tumour parts, thereby suggesting a common lineage, that is, tumour development from a multipotent pancreatic precursor cell.
It may be of interest in this context that Regitnig et al. (already more than 20 years ago) described an insulinoma of the pancreas with insular-ductular differentiation in its liver metastasis, thereby indicating a common stem-cell origin of exocrine and endocrine tumour components.
The current WHO classification (2019) on mixed neuroendocrine-non-neuroendocrine neoplasms (MiNENs) decided against inclusion of mixed malignant/non-malignant (precursor) and mixed non-malignant (precursor; compare ENGIP June 2017) tumours in this category. We agree with the authors of the two cases that were analysed by molecular pathology that the WHO classification should be revised and tumours like the IPMN-NET be included in the MiNEN family.
For further reading
- Regitnig P, Spuller E, Denk H. Insulinoma of the pancreas with insular-ductular differentiation in its liver metastasis--indication of a common stem-cell origin of the exocrine and endocrine components. Virchows Arch. 2001; 438: 624-628. doi: 10.1007/s004280100406.
- Kadota Y, Shinoda M, Tanabe M, Tsujikawa H, Ueno A, Masugi Y, Oshima G, Nishiyama R, Tanaka M, Mihara K, Abe Y, Yagi H, Kitago M, Itano O, Kawachi S, Aiura K, Tanimoto A, Sakamaoto M, Kitagawa Y. Concomitant pancreatic endocrine neoplasm and intraductal papillary mucinous neoplasm: a case report and literature review. World J Surg Oncol. 2013; 11: 75. doi: 10.1186/1477-7819-11-75.
- Ishida M, Shiomi H, Naka S, Tani T, Okabe H. Concomitant intraductal papillary mucinous neoplasm and neuroendocrine tumor of the pancreas. Oncol Lett. 2013; 5: 63-67. doi: 10.3892/ol.2012.952.
- Schlanger D, Popa C, Rusu I, Seicean A, Hajjar NA. Synchronous Pancreatic Tumours: Intraductal Papillary Mucinous Neoplasm with Pancreatic Ductal Adenocarcinoma and Neuroendocrine Tumour: A Case Presentation and Review of Literature. Chirurgia (Bucur). 2021; 116(eCollection): 1-9. doi: 10.21614/chirurgia.116.eC.2425.
- Schiavo Lena M, Cangi MG, Pecciarini L, Francaviglia I, Grassini G, Maire R, Partelli S, Falconi M, Perren A, Doglioni C. Evidence of a common cell origin in a case of pancreatic mixed intraductal papillary mucinous neoplasm-neuroendocrine tumor. Virchows Arch. 2021; 478: 1215-1219. doi: 10.1007/s00428-020-02942-1.
- Chen J, Wang P, Lv K, Zhou W. Case report: composite pancreatic intraductal papillary mucinous neoplasm and neuroendocrine tumor: a new mixed neuroendocrine-non-neuroendocrine neoplasm? Diagn Pathol. 2021; 16: 108. doi: 10.1186/s13000-021-01165-5.
Presented by
Dr. Ana Varelas, Porto, Portugal, and Dr. Cord Langner, Graz, Austria.